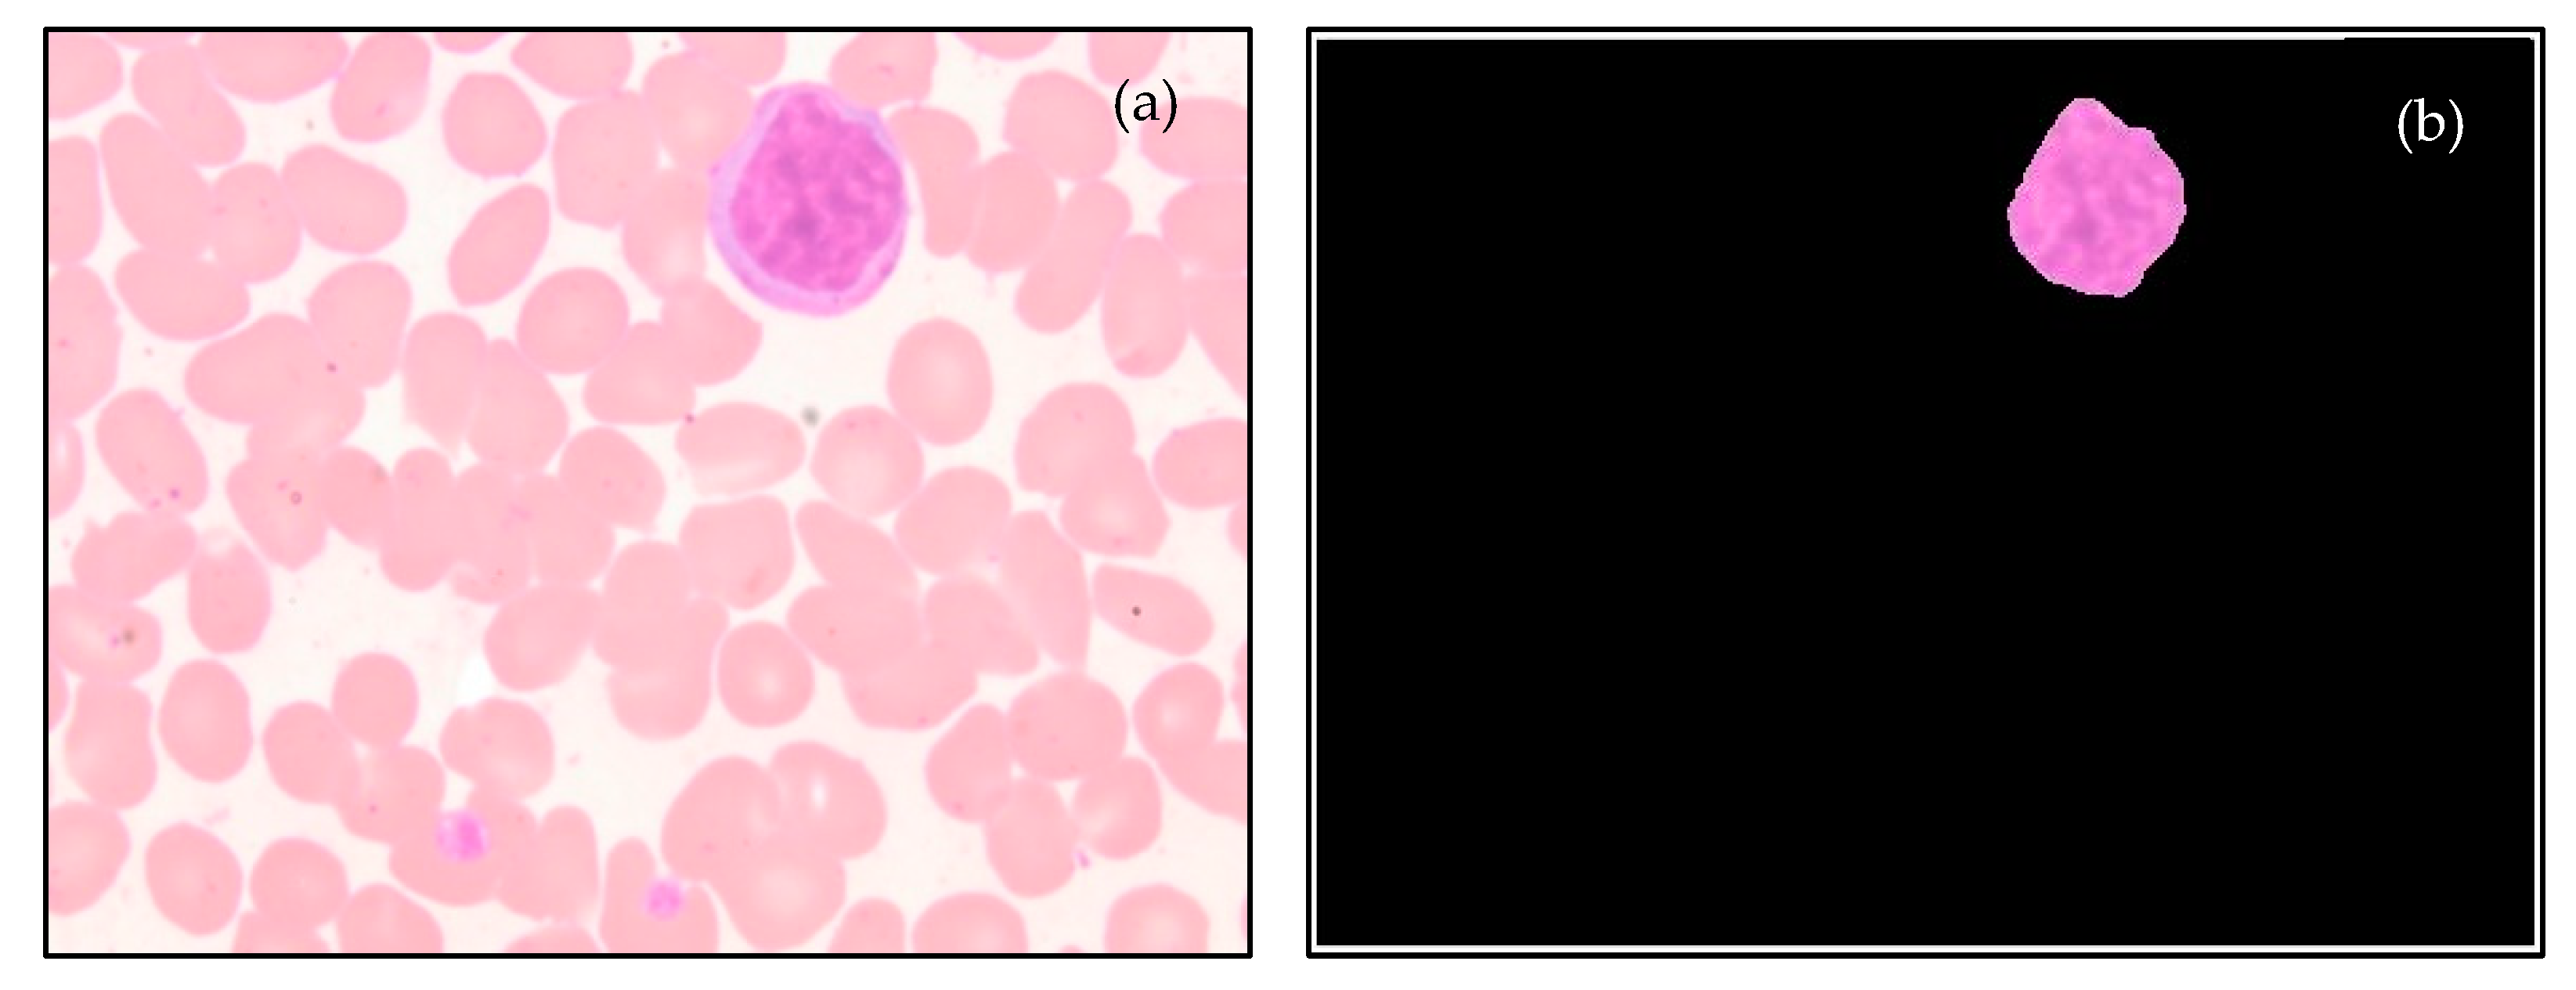
Diagnostics 13 00220 g007 Diagnostics 13 00220 g007
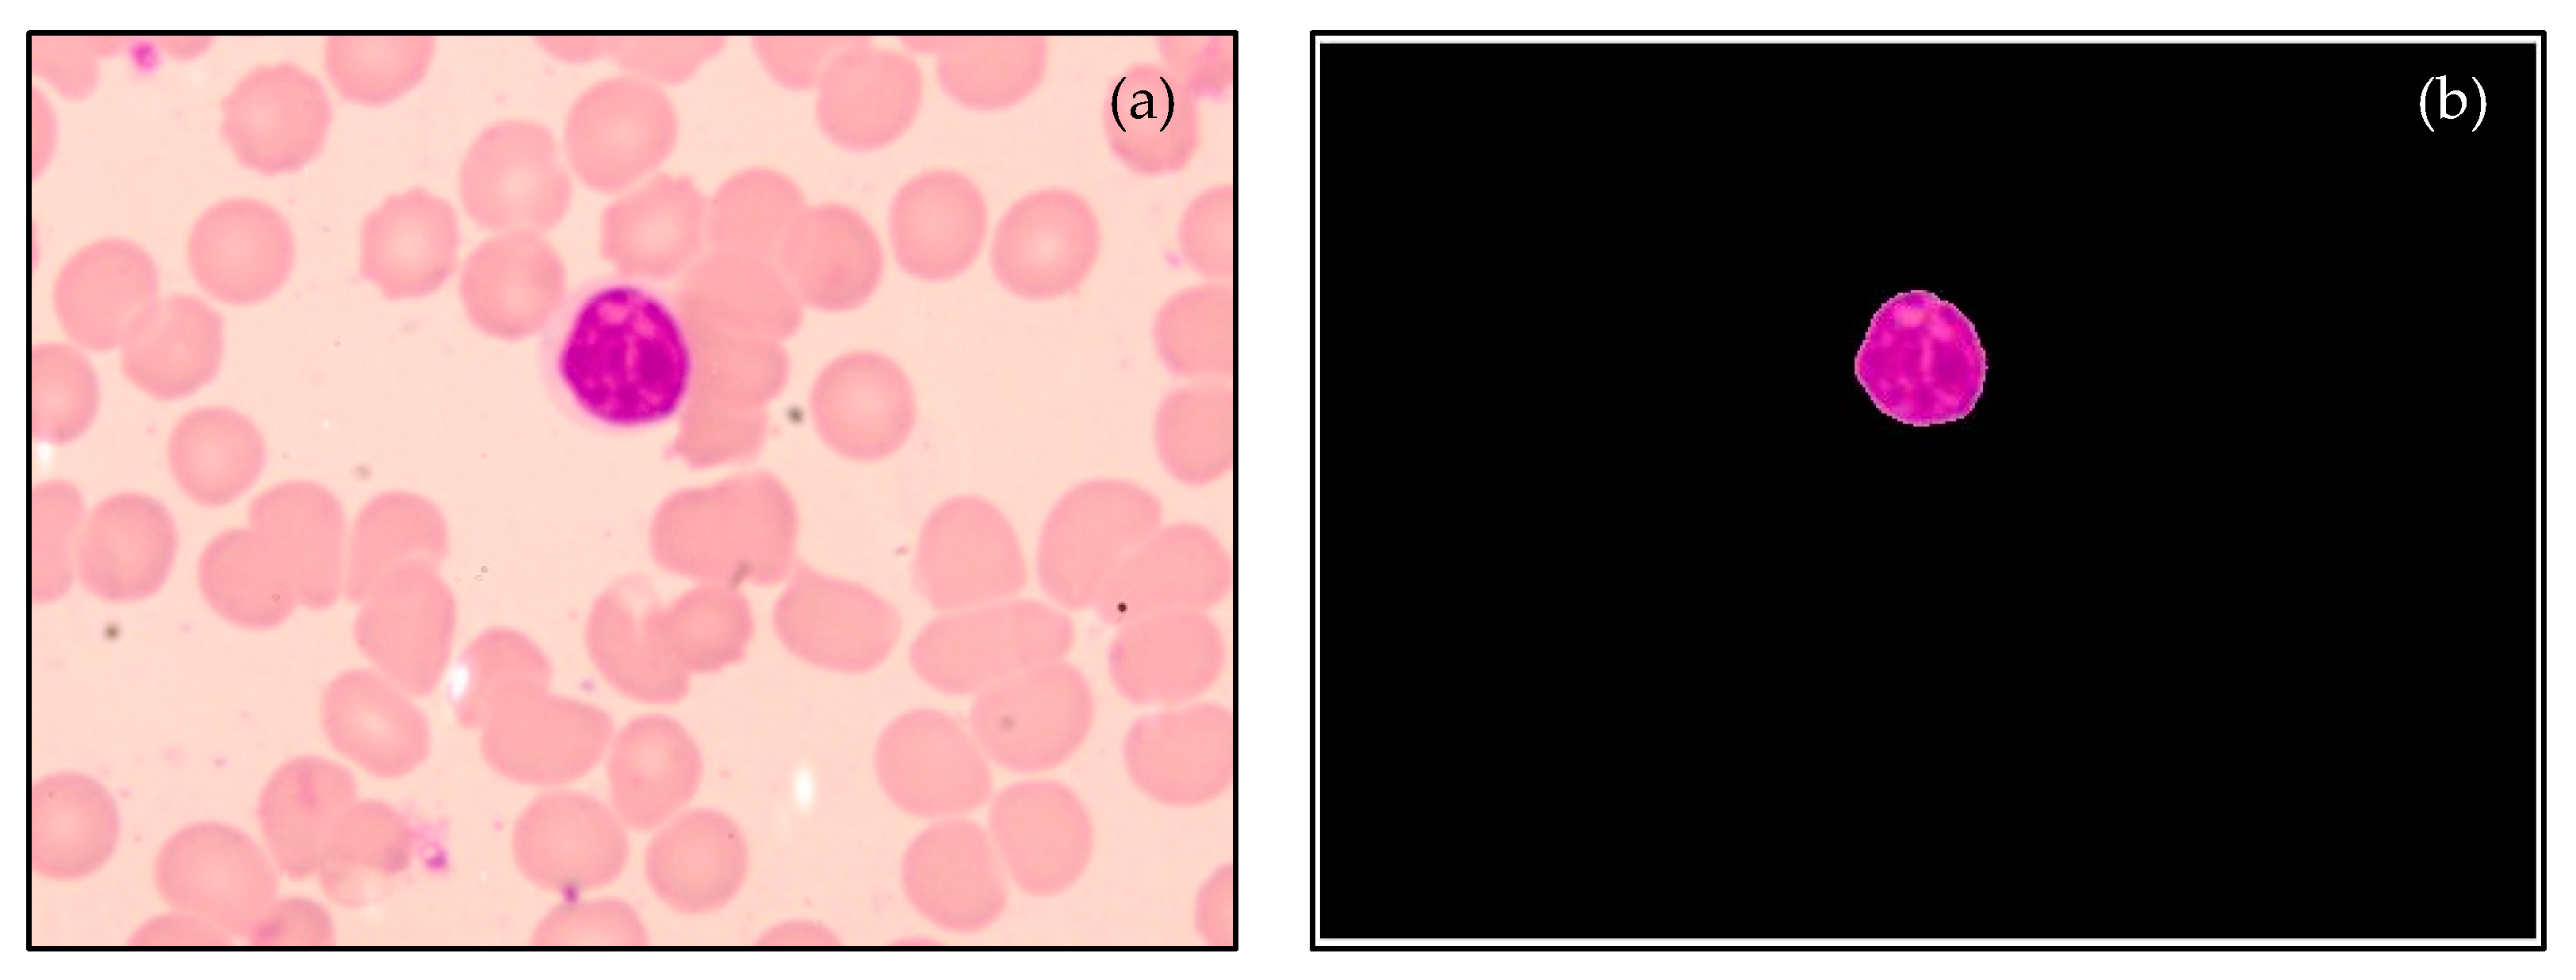
Diagnostics 13 00220 g008 Diagnostics 13 00220 g008

Machine Learning-Based Detection of Dengue from Blood Smear Images Utilizing Platelet and Lymphocyte Characteristics
Abstract
1. Introduction
2. Methodology
2.1. Data Acquisition
2.2. Diagnosis of Thrombocytopenia Using a Blob Detection Algorithm
2.3. Detection of Dengue by Utilizing Morphological Features and GLSDM-Based Textural Features from the Lymphocyte Nucleus
2.3.1. Lymphocyte Nuclei Segmentation
2.3.2. Feature Extraction
- Area
- Perimeter
- Major Axis Length
- Minor Axis Length
- Eccentricity
- Circularity
- Contrast
- Energy
- Correlation
- Homogeneity
2.3.3. Classification
- Decision Tree (DT)
- Linear Discriminant Analysis (LDA)
- Naïve Bayes (NB)
- Support Vector Machine (SVM)
- K-Nearest Neighbor (KNN)
- Multilayer Perceptron (MLP)
2.4. Detection of Dengue by Making Use of MobileNetV2 Deep Features and LBP Textural Features from the Lymphocyte Nucleus
3. Results
3.1. Results of the Blob Detection Algorithm
3.2. Results of Segmentation, Feature Extraction, and Classification for Dengue Detection from the Lymphocyte Nucleus Using Morphological Features/GLSDM-Based Textural Features
3.3. Results of Feature Extraction and Classification for Dengue Detection from the Lymphocyte Nucleus Employing MobileNetV2-Based Deep Features and LBP-Based Textural Features
4. Discussion
5. Conclusions and Future Work
Author Contributions
Funding
Institutional Review Board Statement
Informed Consent Statement
Data Availability Statement
Acknowledgments
Conflicts of Interest
References
- Bouzid, M.; Colón-González, F.J.; Lung, T.; Lake, I.R.; Hunter, P.R. Climate change and the emergence of vector-borne diseases in Europe: Case study of dengue fever. BMC Public Health 2014, 14, 781. [Google Scholar] [CrossRef] [PubMed]
- Jing, Q.; Wang, M. Dengue epidemiology. Glob. Heal. J. 2019, 3, 37–45. [Google Scholar] [CrossRef]
- WHO. Dengue and Severe Dengue, WHO Fact Sheets. 2022. Available online: https://www.who.int/news-room/fact-sheets/detail/dengue-and-severe-dengue (accessed on 3 June 2022).
- Khetarpal, N.; Khanna, I. Dengue Fever: Causes, Complications, and Vaccine Strategies. J. Immunol. Res. 2016, 2016, 6803098. [Google Scholar] [CrossRef] [PubMed]
- Messina, J.P.; Brady, O.J.; Golding, N.; Kraemer, M.U.G.; Wint, G.R.W.; Ray, S.E.; Pigott, D.M.; Shearer, F.M.; Johnson, K.; Earl, L.; et al. The current and future global distribution and population at risk of dengue. Nat. Microbiol. 2019, 4, 1508–1515. [Google Scholar] [CrossRef]
- Hasan, S.; Jamdar, S.; Alalowi, M.; Al Ageel Al Beaiji, S. Dengue virus: A global human threat: Review of literature. J. Int. Soc. Prev. Community Dent. 2016, 6, 1. [Google Scholar] [CrossRef] [PubMed]
- Muller, D.A.; Depelsenaire, A.C.I.; Young, P.R. Clinical and Laboratory Diagnosis of Dengue Virus Infection. J. Infect. Dis. 2017, 215, S89–S95. [Google Scholar] [CrossRef]
- Wilder-Smith, A.; Ooi, E.-E.; Horstick, O.; Wills, B. Dengue. Lancet 2019, 393, 350–363. [Google Scholar] [CrossRef]
- Chaloemwong, J.; Tantiworawit, A.; Rattanathammethee, T.; Hantrakool, S.; Chai-Adisaksopha, C.; Rattarittamrong, E.; Norasetthada, L. Useful clinical features and hematological parameters for the diagnosis of dengue infection in patients with acute febrile illness: A retrospective study. BMC Hematol. 2018, 18, 20. [Google Scholar] [CrossRef]
- Mayrose, H.; Sampathila, N.; Bairy, G.M.; Belurkar, S.; Saravu, K.; Basu, A.; Khan, S. Intelligent algorithm for detection of dengue using mobilenetv2-based deep features with lymphocyte nucleus. Expert Syst. 2021, e12904. [Google Scholar] [CrossRef]
- Khandekar, R.; Shastry, P.; Jaishankar, S.; Faust, O.; Sampathila, N. Automated blast cell detection for Acute Lymphoblastic Leukemia diagnosis. Biomed. Signal Process Control. 2021, 68, 102690. [Google Scholar] [CrossRef]
- Hegde, R.B.; Prasad, K.; Hebbar, H.; Sandhya, I. Peripheral blood smear analysis using image processing approach for diagnostic purposes: A review. Biocybern. Biomed. Eng. 2018, 38, 467–480. [Google Scholar] [CrossRef]
- Di Ruberto, C.; Loddo, A.; Puglisi, G. Blob Detection and Deep Learning for Leukemic Blood Image Analysis. Appl. Sci. 2020, 10, 1176. [Google Scholar] [CrossRef]
- Niazi, M.K.K.; Parwani, A.V.; Gurcan, M.N. Digital pathology and artificial intelligence. Lancet Oncol. 2019, 20, e253–e261. [Google Scholar] [CrossRef] [PubMed]
- Parwani, A.V. Next generation diagnostic pathology: Use of digital pathology and artificial intelligence tools to augment a pathological diagnosis. Diagn. Pathol. 2019, 14, 1–3. [Google Scholar] [CrossRef] [PubMed]
- Das, P.K.; Diya, A.V.; Meher, S.; Panda, R.; Abraham, A. A Systematic Review on Recent Advancements in Deep and Machine Learning Based Detection and Classification of Acute Lymphoblastic Leukemia. IEEE Access 2022, 10, 81741–81763. [Google Scholar] [CrossRef]
- Das, P.K.; Sahoo, B.; Meher, S. An Efficient Detection and Classification of Acute Leukemia using Transfer Learning and Orthogonal Softmax Layer-based Model. IEEE/ACM Trans. Comput. Biol. Bioinforma. 2022, 1–12. [Google Scholar] [CrossRef]
- Das, P.K.; Pradhan, A.; Meher, S. Detection of Acute Lymphoblastic Leukemia Using Machine Learning Techniques. In Machine Learning, Deep Learning and Computational Intelligence for Wireless Communication; Springer: Berlin/Heidelberg, Germany, 2021; pp. 425–437. [Google Scholar]
- Das, P.K.; Nayak, B.; Meher, S. A lightweight deep learning system for automatic detection of blood cancer. Measurement 2022, 191, 110762. [Google Scholar] [CrossRef]
- Das, P.K.; Meher, S. An efficient deep Convolutional Neural Network based detection and classification of Acute Lymphoblastic Leukemia. Expert Syst. Appl. 2021, 183, 115311. [Google Scholar] [CrossRef]
- Das, P.K.; Meher, S.; Panda, R.; Abraham, A. A Review of Automated Methods for the Detection of Sickle Cell Disease. IEEE Rev. Biomed. Eng. 2020, 13, 309–324. [Google Scholar] [CrossRef]
- Krishnadas, P.; Chadaga, K.; Sampathila, N.; Rao, S.; Swathi, K.S.; Prabhu, S. Classification of Malaria Using Object Detection Models. Informatics 2022, 9, 76. [Google Scholar] [CrossRef]
- Ojha, A.; Nandi, D.; Batra, H.; Singhal, R.; Annarapu, G.K.; Bhattacharyya, S.; Seth, T.; Dar, L.; Medigeshi, G.R.; Vrati, S.; et al. Platelet activation determines the severity of thrombocytopenia in dengue infection. Sci. Rep. 2017, 7, 41697. [Google Scholar] [CrossRef] [PubMed]
- Hottz, E.; Tolley, N.D.; Zimmerman, G.A.; Weyrich, A.S.; Bozza, F.A. Platelets in dengue infection. Drug Discov. Today Dis. Mech. 2011, 8, e33–e38. [Google Scholar] [CrossRef]
- Naik, M.; Bhat, T.; Wani, A.A.; Amin, A.; Jalaalie, U. Clinical and Laboratory Profile of Dengue in Kashmir Valley. J. Assoc. Physicians India 2022, 69, 11–12. [Google Scholar] [PubMed]
- Ralapanawa, U.; Alawattegama, A.T.M.; Gunrathne, M.; Tennakoon, S.; Kularatne, S.A.M.; Jayalath, T. Value of peripheral blood count for dengue severity prediction. BMC Res. Notes 2018, 11, 400. [Google Scholar] [CrossRef]
- Mabood, A.; Chaturvedi, V.; Gupta, S.; Alam, M.Q.; Dwivedi, N.; Agarwal, S.; Pandey, p. Thrombocyte estimation based on blood smear and its comparison using automated haematology analysers. J. Evol. Med. Dent. Sci. 2019, 8, 1588–1591. [Google Scholar] [CrossRef]
- Gole, S.G.; Krishna, M.; Gole, G.N. Comparison Study of Platelet Count Estimation by Two Methodologies: An Automated Hematologyanalyzer and Peripheral Blood Smear Examination. Indian J. Pathol. Res. Pract. 2018, 7, 905–909. [Google Scholar] [CrossRef]
- Yunus, Y.M. Morphological Features Analysis in Pathogenic Dengue Infection as an Alternative Screening Method. Int. J. Acad. Res. Bus. Soc. Sci. 2017, 7, 801–811. [Google Scholar]
- Clarice, C.S.H.; Abeysuriya, V.; De Mel, S.; Thilakawardana, B.U.; De Mel, P.; De Mel, C.; Chandrasena, L.; Seneviratne, S.L.; Yip, C.; Yap, E.S. Atypical lymphocyte count correlates with the severity of dengue infection. PLoS ONE 2019, 14, e0215061. [Google Scholar] [CrossRef]
- Datta, L.; Menon, M.P. Plasmacytoid lymphocytes: A clue to dengue diagnosis. Blood 2017, 129, 2202. [Google Scholar] [CrossRef]
- Tanaka, Y. Plasmacytoid Lymphocytes: A Diagnostic Clue for Dengue Fever. Intern. Med. 2018, 57, 0179-17. [Google Scholar] [CrossRef]
- Saikia, D.; Dutta, J.C. Early diagnosis of dengue disease using fuzzy inference system. In Proceedings of the 2016 International Conference on Microelectronics, Computing and Communications (MicroCom), Durgapur, India, 23–25 January 2016; pp. 1–6. [Google Scholar] [CrossRef]
- Shimpi, P.; Shah, S.; Shroff, M.; Godbole, A. An artificial neural network approach for classification of vector-borne diseases. In Proceedings of the 2017 International Conference on Computing Methodologies and Communication (ICCMC), Erode, India, 18–19 July 2017; pp. 412–415. [Google Scholar] [CrossRef]
- Zainee, N.B.M.; Chellappan, K. A preliminary dengue fever prediction model based on vital signs and blood profile. In Proceedings of the 2016 IEEE EMBS Conference on Biomedical Engineering and Sciences (IECBES), Kuala Lumpur, Malaysia, 4–8 December 2016; pp. 652–656. [Google Scholar] [CrossRef]
- Caicedo-Torres, W.; Paternina, A.; Pinzon, H. Machine Learning Models for Early Dengue Severity Prediction. In Advances in Artificial Intelligence–IBERAMIA 2016; Springer: Berlin/Heidelberg, Germany, 2016; pp. 247–258. [Google Scholar]
- Hossain, M.S.; Habib, I.B. A belief rule based expert system to diagnose dengue fever under uncertainty. In Proceedings of the 2017 Computing Conference, London, UK, 18–20 July 2017; pp. 179–186. [Google Scholar] [CrossRef]
- Tuan, N.M.; Nhan, H.T.; Chau, N.V.V.; Hung, N.T.; Tuan, H.M.; Van Tram, T.; Le Da Ha, N.; Loi, P.; Quang, H.K.; Kien, D.T.H.; et al. Sensitivity and Specificity of a Novel Classifier for the Early Diagnosis of Dengue. PLOS Neglected Trop. Dis. 2015, 9, e0003638. [Google Scholar] [CrossRef] [PubMed]
- Fernandez, E.P.-A.; Smieja, M.; Walter, S.D.; Loeb, M. A predictive model to differentiate dengue from other febrile illness. BMC Infect. Dis. 2016, 16, 1–7. [Google Scholar] [CrossRef] [PubMed]
- Mello-Román, J.D.; Mello-Román, J.C.; Gómez-Guerrero, S.; García-Torres, M. Predictive Models for the Medical Diagnosis of Dengue: A Case Study in Paraguay. Comput. Math. Methods Med. 2019, 2019, 7307803. [Google Scholar] [CrossRef] [PubMed]
- Gambhir, S.; Malik, S.K.; Kumar, Y. PSO-ANN based diagnostic model for the early detection of dengue disease. New Horiz. Transl. Med. 2017, 4, 1–8. [Google Scholar] [CrossRef]
- Mahesh, G.; Dhume, M.; Rahul, S.; Belurkar, S.; Sampathila, N. Detection of Dengue Utilizing Platelet count through Image Processing Techniques. J. Adv. Res. Dyn. Control Syst. 2017, 853–859. [Google Scholar]
- Poornima, J.; Krishnaveni, K. Detection of Dengue Fever with Platelets Count using Image Processing Techniques. Indian J. Sci. Technol. 2016, 9, 1–7. [Google Scholar] [CrossRef]
- Ghosh, P.; Dey, R.; Roy, K.; Bhattacharjee, D.; Nashipuri, M. Microscopic Image Segmentation Using Hy-brid Technique for Dengue Prediction. In Hybrid Soft Computing for Image Segmentation; Springer In-ternational Publishing: Cham, Switzerland, 2016; pp. 109–136. [Google Scholar]
- Tantikitti, S.; Tumswadi, S.; Premchaiswadi, W. Image processing for detection of dengue virus based on WBC classification and decision tree. In Proceedings of the 2015 13th International Conference on ICT and Knowledge Engineering (ICT & Knowledge Engineering 2015), Bangkok, Thailand, 18–20 November 2015; pp. 84–89. [Google Scholar] [CrossRef]
- Cruz, D.; Jennifer, C.; Valiente; Castor, L.C.; Mendoza, C.M.T.; Jay, B.A.; Jane, L.S.C.; Brian, P.T.B. Determination of blood components (WBCs, RBCs, and Platelets) count in microscopic images using image processing and analysis. In Proceedings of the 2017 IEEE 9th International Conference on Humanoid, Nanotechnology, Information Technology, Communication and Control, Environment and Management (HNICEM), Manila, Philippines, 1–3 December 2017; IEEE: Piscataway, NJ, USA, 2017; pp. 1–7. [Google Scholar]
- Christy Evangeline, N.; Annalatha, M. Computer Aided System for Human Blood Cell Identification, Classification and Counting. In Proceedings of the 2018 Fourth International Conference on Biosignals, Images and Instrumentation (ICBSII), Chennai, India, 22–24 March 2018; IEEE: Piscataway, NJ, USA, 2018; pp. 206–212. [Google Scholar]
- Meimban, R.J.; Ray Fernando, A.; Monsura, A.; Ranada, J.; Apduhan, J. Blood Cells Counting using Python OpenCV. In Proceedings of the 2018 14th IEEE International Conference on Signal Processing (ICSP), Beijing, China, 12–16 August 2018; IEEE: Piscataway, NJ, USA, 2018; pp. 50–53. [Google Scholar]
- Mahanta, L.B.; Bora, K.; Kalita, S.J.; Yogi, P. Automated Counting of Platelets and White Blood Cells from Blood Smear Images. In Pattern Recognition and Machine Intelligence; Springer: Berlin/Heidelberg, Germany, 2019; pp. 13–20. [Google Scholar]
- Monteiro, A.M.; Iano, Y.; França, R.; Arthur, R. Medical-Laboratory Algorithm WTH-MO for Segmentation of Digital Images of Blood Cells: A New Methodology for Making Hemograms. Int. J. Simul. Syst. Sci. Technol. 2019, 20, 19.1–19.5. [Google Scholar] [CrossRef]
- Alam, M.M.; Islam, M.T. Machine learning approach of automatic identification and counting of blood cells. Healthc. Technol. Lett. 2019, 6, 103–108. [Google Scholar] [CrossRef]
- Manik, S.; Saini, L.M.; Vadera, N. Counting and classification of white blood cell using Artificial Neural Network (ANN). In Proceedings of the 2016 IEEE 1st International Conference on Power Electronics, Intelligent Control and Energy Systems (ICPEICES), Delhi, India, 4–6 July 2016; IEEE: Piscataway, NJ, USA, 2016; pp. 1–5. [Google Scholar]
- Sajjad, M.; Khan, S.; Shoaib, M.; Ali, H.; Jan, Z.; Muhammad, K.; Mehmood, I. Computer Aided System for Leukocytes Classification and Segmentation in Blood Smear Images. In Proceedings of the 2016 International Conference on Frontiers of Information Technology (FIT), Islamabad, Pakistan, 19–21 December 2016; IEEE: Piscataway, NJ, USA, 2016; pp. 99–104. [Google Scholar]
- Shahin, A.I.; Guo, Y.; Amin, K.M.; Sharawi, A.A. White blood cells identification system based on convolutional deep neural learning networks. Comput. Methods Programs Biomed. 2019, 168, 69–80. [Google Scholar] [CrossRef]
- Hegde, R.B.; Prasad, K.; Hebbar, H.; Singh, B.M.K. Comparison of traditional image processing and deep learning approaches for classification of white blood cells in peripheral blood smear images. Biocybern. Biomed. Eng. 2019, 39, 382–392. [Google Scholar] [CrossRef]
- Hegde, R.B.; Prasad, K.; Hebbar, H.; Singh, B.M.K. Image Processing Approach for Detection of Leukocytes in Peripheral Blood Smears. J. Med. Syst. 2019, 43, 114. [Google Scholar] [CrossRef] [PubMed]
- Banik, P.P.; Saha, R.; Kim, K.-D. An Automatic Nucleus Segmentation and CNN Model based Classification Method of White Blood Cell. Expert Syst. Appl. 2020, 149, 113211. [Google Scholar] [CrossRef]
- Aziz, S.; Bilal, M.; Khan, M.U.; Amjad, F. Deep Learning-based Automatic Morphological Classification of Leukocytes using Blood Smears. In Proceedings of the 2020 International Conference on Electrical, Communication, and Computer Engineering (ICECCE), Istanbul, Turkey, 12–13 June 2020; IEEE: Piscataway, NJ, USA, 2020; pp. 1–5. [Google Scholar]
- Sapna, S.; Renuka, A. Computer-aided system for Leukocyte nucleus segmentation and Leukocyte classification based on nucleus characteristics. Int. J. Comput. Appl. 2020, 42, 622–633. [Google Scholar] [CrossRef]
- Toğaçar, M.; Ergen, B.; Cömert, Z. Classification of white blood cells using deep features obtained from Convolutional Neural Network models based on the combination of feature selection methods. Appl. Soft Comput. 2020, 97, 106810. [Google Scholar] [CrossRef]
- Cinar, A.; Tuncer, S.A. Classification of lymphocytes, monocytes, eosinophils, and neutrophils on white blood cells using hybrid Alexnet-GoogleNet-SVM. SN Appl. Sci. 2021, 3, 1–11. [Google Scholar] [CrossRef]
- Blob Detection Using OpenCV ( Python, C++ ). Available online: https://learnopencv.com/blob-detection-using-opencv-python-c/ (accessed on 1 March 2021).
- Mayrose, H.; Niranjana, S.; Bairy, G.M.; Edwankar, H.; Belurkar, S.; Saravu, K. Computer Vision Approach for the detection of Thrombocytopenia from Microscopic Blood Smear Images. In Proceedings of the 2021 IEEE International Conference on Electronics, Computing and Communication Technologies (CONECCT), Bangalore, India, 9–11 July 2021; IEEE: Piscataway, NJ, USA, 2021; pp. 1–5. [Google Scholar]
- Cicolani, J. An Introduction to OpenCV. In Beginning Robotics with Raspberry Pi and Arduino; Apress: Berkeley, CA, USA, 2018; pp. 297–341. [Google Scholar]
- Andrade, A.R.; Vogado, L.H.S.; de M.S. Veras, R.; Silva, R.R.V.; Araujo, F.H.D.; Medeiros, F.N.S. Recent computational methods for white blood cell nuclei segmentation: A comparative study. Comput. Methods Programs Biomed. 2019, 173, 1–14. [Google Scholar] [CrossRef] [PubMed]
- Madhloom, H.T.; Kareem, S.A.; Ariffin, H.; Zaidan, A.A. An Automated White Blood Cell Nucleus Localization and Segmentation using Image Arithmetic and Automatic Threshold. J. Appl. Sci. 2010, 10, 959–966. [Google Scholar] [CrossRef]
- MathWorks (R2022a): Measure properties of image regions. 2022. Available online: https://in.mathworks.com/help/images/ref/regionprops.html (accessed on 5 May 2022).
- Hegde, R.B.; Prasad, K.; Hebbar, H.; Singh, B.M.K. Development of a Robust Algorithm for Detection of Nuclei and Classification of White Blood Cells in Peripheral Blood Smear Images. J. Med. Syst. 2018, 42, 110. [Google Scholar] [CrossRef]
- Sampathila, N.; Pavithra; Martis, R.J. Computational approach for content-based image retrieval of K-similar images from brain MR image database. Expert Syst. 2020, 39, e12652. [Google Scholar] [CrossRef]
- Hossain, M.R.I.; Ahmed, I.; Kabir, M.H. Automatic Lung Tumor Detection Based on GLCM Features. In Computer Vision-ACCV 2014 Workshops; Springer: Berlin/Heidelberg, Germany, 2015; pp. 109–121. [Google Scholar]
- Tang, Z.; Su, Y.; Er, M.J.; Qi, F.; Zhang, L.; Zhou, J. A local binary pattern based texture descriptors for classification of tea leaves. Neurocomputing 2015, 168, 1011–1023. [Google Scholar] [CrossRef]
- Acharya, U.R.; Faust, O.; Sree, S.V.; Molinari, F.; Suri, J.S. ThyroScreen system: High resolution ultrasound thyroid image characterization into benign and malignant classes using novel combination of texture and discrete wavelet transform. Comput. Methods Programs Biomed. 2012, 107, 233–241. [Google Scholar] [CrossRef] [PubMed]
- Acharya, U.R.; Faust, O.; Sree, S.V.; Molinari, F.; Garberoglio, R.; Suri, J.S. Cost-Effective and Non-Invasive Automated Benign & Malignant Thyroid Lesion Classification in 3D Contrast-Enhanced Ultrasound Using Combination of Wavelets and Textures: A Class of ThyroScanTM Algorithms. Technol. Cancer Res. Treat. 2011, 10, 371–380. [Google Scholar] [CrossRef] [PubMed]
- Acharya, U.R.; Ng, E.Y.K.; Tan, J.-H.; Sree, S.V.; Ng, K.-H. An Integrated Index for the Identification of Diabetic Retinopathy Stages Using Texture Parameters. J. Med. Syst. 2012, 36, 2011–2020. [Google Scholar] [CrossRef] [PubMed]
- RAcharya, R.U.; Faust, O.; Alvin, A.P.C.; Sree, S.V.; Molinari, F.; Saba, L.; Nicolaides, A.; Suri, J.S. Symptomatic vs. Asymptomatic Plaque Classification in Carotid Ultrasound. J. Med Syst. 2011, 36, 1861–1871. [Google Scholar] [CrossRef] [PubMed]
- Acharya, U.R.; Ng, E.Y.K.; Tan, J.-H.; Sree, S.V. Thermography Based Breast Cancer Detection Using Texture Features and Support Vector Machine. J. Med Syst. 2010, 36, 1503–1510. [Google Scholar] [CrossRef] [PubMed]
- Ossai, C.I.; Wickramasinghe, N. GLCM and statistical features extraction technique with Extra-Tree Classifier in Macular Oedema risk diagnosis. Biomed. Signal Process. Control 2022, 73, 103471. [Google Scholar] [CrossRef]
- Sharma, M.; Patel, S.; Acharya, U.R. Expert system for detection of congestive heart failure using optimal wavelet and heart rate variability signals for wireless cloud-based environment. Expert Syst. 2021, e12903. [Google Scholar] [CrossRef]
- Taye, G.T.; Hwang, H.-J.; Lim, K.M. Application of a convolutional neural network for predicting the occurrence of ventricular tachyarrhythmia using heart rate variability features. Sci. Rep. 2020, 10, 6769. [Google Scholar] [CrossRef]
- Shobha, G.; Rangaswamy, S. Machine Learning. Handb. Stat. 2018, 38, 197–228. [Google Scholar]
- Baygin, M.; Dogan, S.; Tuncer, T.; Datta Barua, P.; Faust, O.; Arunkumar, N.; Abdulhay, E.W.; Emma Palmer, E.; Rajendra Acharya, U. Automated ASD detection using hybrid deep lightweight features extracted from EEG signals. Comput. Biol. Med. 2021, 134, 104548. [Google Scholar] [CrossRef]
- Ali, L.; Zhu, C.; Zhang, Z.; Liu, Y. Automated Detection of Parkinson’s Disease Based on Multiple Types of Sustained Phonations Using Linear Discriminant Analysis and Genetically Optimized Neural Network. IEEE J. Transl. Eng. Heal. Med. 2019, 7, 1–10. [Google Scholar] [CrossRef] [PubMed]
- Noronha, K.P.; Acharya, U.R.; Nayak, K.P.; Martis, R.J.; Bhandary, S.V. Automated classification of glaucoma stages using higher order cumulant features. Biomed. Signal Process. Control 2014, 10, 174–183. [Google Scholar] [CrossRef]
- Krishnan, S. Machine learning for biomedical signal analysis. In Biomedical Signal Analysis for Connected Healthcare; Elsevier: Amsterdam, The Netherlands, 2021; pp. 223–264. [Google Scholar]
- Rajendra Acharya, U.; Vinitha Sree, S.; Muthu Rama Krishnan, M.; Molinari, F.; Garberoglio, R.; Suri, J.S. Non-invasive automated 3D thyroid lesion classification in ultrasound: A class of ThyroScanTM systems. Ultrasonics 2012, 52, 508–520. [Google Scholar] [CrossRef] [PubMed]
- Chadaga, K.; Prabhu, S.; Vivekananda, B.K.; Niranjana, S.; Umakanth, S. Battling COVID-19 using machine learning: A review. Cogent Eng. 2021, 8, 1958666. [Google Scholar] [CrossRef]
- Acharya, U.R.; Akter, A.; Chowriappa, P.; Dua, S.; Raghavendra, U.; Koh, J.E.W.; Tan, J.H.; Leong, S.S.; Vijayananthan, A.; Hagiwara, Y.; et al. Use of Nonlinear Features for Automated Characterization of Suspicious Ovarian Tumors Using Ultrasound Images in Fuzzy Forest Framework. Int. J. Fuzzy Syst. 2018, 20, 1385–1402. [Google Scholar] [CrossRef]
- Acharya, U.R.; Chowriappa, P.; Fujita, H.; Bhat, S.; Dua, S.; Koh, J.E.W.; Eugene, L.W.J.; Kongmebhol, P.; Ng, K.H. Thyroid lesion classification in 242 patient population using Gabor transform features from high resolution ultrasound images. Knowledge-Based Syst. 2016, 107, 235–245. [Google Scholar] [CrossRef]
- Nayak, J.; Acharya, U.R.; Bhat, P.S.; Shetty, N.; Lim, T.-C. Automated Diagnosis of Glaucoma Using Digital Fundus Images. J. Med. Syst. 2009, 33, 337–346. [Google Scholar] [CrossRef]
- Hoyos, W.; Aguilar, J.; Toro, M. Dengue models based on machine learning techniques: A systematic literature review. Artif. Intell. Med. 2021, 119, 102157. [Google Scholar] [CrossRef]
- Katta, M.; Sandanalakshmi, R.; Srilakshmi, G.; Adireddi, R. An Efficient Learning Model Selection for Dengue Detection. In Smart Innovation, Systems and Technologies; Springer: Berlin/Heidelberg, Germany, 2022; pp. 439–453. ISBN 978-981169872-9. [Google Scholar]
- Hoyos, W.; Aguilar, J.; Toro, M. A clinical decision-support system for dengue based on fuzzy cognitive maps. Health Care Manag. Sci. 2022, 25, 666–681. [Google Scholar] [CrossRef]

| Classifier | Parameters | Value |
|---|---|---|
| DT | Preset Splits Split Criterion Surrogate Decision Splits | Fine Tree 100 Gini’s Diversity Index Off |
| LDA | Preset Covariance Structure | Linear Discriminant Full |
| NB | Preset Distribution of Numeric Predictors | GaussianNaive Bayes Gaussian |
| SVM | Preset Kernel Function Kernel Scale Box Constraint Level Standardize Data | Quadratic SVM Quadratic Automatic 1 True |
| KNN | Preset Neighbors Distance Metric Distance Weight Standardize Data | Fine KNN 1 Euclidean Equal True |
| MLP | Preset Fully Connected Layers First Layer Size Activation Iteration Limit Standardize Data | Narrow Neural Network 1 10 ReLU 1000 Yes |
| Patient Number | Machine Count | Algorithm Count |
|---|---|---|
| 1 | 42,000 | 45,000 |
| 2 | 113,000 | 108,000 |
| 3 | 35,000 | 36,000 |
| 4 | 41,000 | 31,500 |
| 5 | 80,000 | 81,000 |
| 6 | 8000 | 9000 |
| 7 | 16,000 | 18,000 |
| 8 | 18,000 | 13,500 |
| 9 | 73,000 | 76,500 |
| 10 | 61,000 | 67,500 |
| Classifier | Acc (%) | Sen (%) | Spe (%) | Pre (%) | F1 (%) | AUC |
|---|---|---|---|---|---|---|
| DT | 93.62 | 92.59 | 95.00 | 96.15 | 94.34 | 0.96 |
| LDA | 92.55 | 94.44 | 90.00 | 92.73 | 93.58 | 0.96 |
| NB | 86.17 | 77.77 | 97.50 | 97.67 | 86.59 | 0.97 |
| SVM | 93.62 | 92.59 | 95.00 | 96.15 | 94.34 | 0.96 |
| KNN | 87.23 | 85.19 | 90.00 | 92.00 | 88.46 | 0.88 |
| MLP | 92.55 | 96.30 | 87.50 | 91.23 | 93.70 | 0.94 |
| Classifier | Acc (%) | Sen (%) | Spe (%) | Pre (%) | F1 (%) | AUC |
|---|---|---|---|---|---|---|
| DT | 75.53 | 77.78 | 72.50 | 79.25 | 73.18 | 0.80 |
| LDA | 93.62 | 96.30 | 90.00 | 92.86 | 94.55 | 0.93 |
| NB | 88.30 | 92.59 | 82.50 | 87.72 | 90.09 | 0.94 |
| SVM | 95.74 | 98.15 | 92.50 | 94.64 | 96.36 | 0.98 |
| KNN | 91.49 | 90.74 | 92.50 | 94.23 | 92.45 | 0.92 |
| MLP | 94.68 | 94.44 | 95.00 | 96.23 | 95.33 | 0.96 |
| Article | Attributes | Method | Validation | Acc (%) |
|---|---|---|---|---|
| Gambhir et al. (2017) [41] | 16 features (symptoms, vital signs, and blood profile data) | PSO-ANN ANN | 10-fold cross-validation | 87.27 79.09 |
| Mello-Roman et al. (2019) [40] | 38 features (symptoms) | MLP SVM | 90:10 split test | 96.00 92.00 |
| Katta et al. (2021) [91] | Symptoms | RF Adaboost M1 | 64:36 split test | 94.39 92.90 |
| Hoyos et al. (2022) [92] | 22 features (symptoms, vital signs, and blood profile data) | FCM | 10-fold cross-validation | 89.40 |
| Mayrose et al. (2021) [10] | 100 Deep/LBP features of Lymphocyte nuclei from PBS | SVM MLP | 10-fold cross-validation | 95.74 94.68 |
| Proposed work (2022) | 10 Morphological/GLSDM features of Lymphocyte nuclei from PBS | SVM DT | 10-fold cross-validation | 93.62 93.62 |
Disclaimer/Publisher’s Note: The statements, opinions and data contained in all publications are solely those of the individual author(s) and contributor(s) and not of MDPI and/or the editor(s). MDPI and/or the editor(s) disclaim responsibility for any injury to people or property resulting from any ideas, methods, instructions or products referred to in the content. |
© 2023 by the authors. Licensee MDPI, Basel, Switzerland. This article is an open access article distributed under the terms and conditions of the Creative Commons Attribution (CC BY) license (https://creativecommons.org/licenses/by/4.0/).
Share and Cite
Mayrose, H.; Bairy, G.M.; Sampathila, N.; Belurkar, S.; Saravu, K. Machine Learning-Based Detection of Dengue from Blood Smear Images Utilizing Platelet and Lymphocyte Characteristics. Diagnostics 2023, 13, 220. https://doi.org/10.3390/diagnostics13020220
Mayrose H, Bairy GM, Sampathila N, Belurkar S, Saravu K. Machine Learning-Based Detection of Dengue from Blood Smear Images Utilizing Platelet and Lymphocyte Characteristics. Diagnostics. 2023; 13(2):220. https://doi.org/10.3390/diagnostics13020220
Chicago/Turabian StyleMayrose, Hilda, G. Muralidhar Bairy, Niranjana Sampathila, Sushma Belurkar, and Kavitha Saravu. 2023. "Machine Learning-Based Detection of Dengue from Blood Smear Images Utilizing Platelet and Lymphocyte Characteristics" Diagnostics 13, no. 2: 220. https://doi.org/10.3390/diagnostics13020220
APA StyleMayrose, H., Bairy, G. M., Sampathila, N., Belurkar, S., & Saravu, K. (2023). Machine Learning-Based Detection of Dengue from Blood Smear Images Utilizing Platelet and Lymphocyte Characteristics. Diagnostics, 13(2), 220. https://doi.org/10.3390/diagnostics13020220

